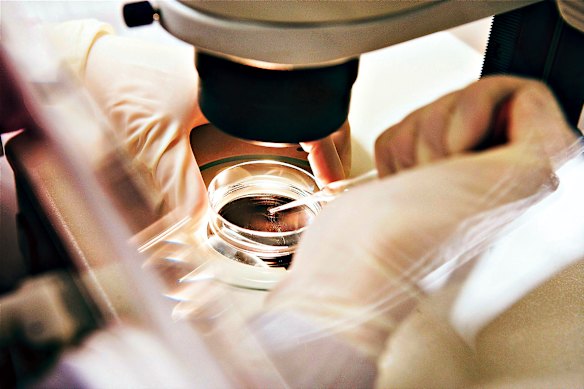
More Australian researchers are applying for grants each year, but the amount of money available has stayed relatively static.

More than nine in 10 Australian medical researchers who applied for government-funded innovation grants last year were rejected at the same time that Australia’s medical investment fund sits on almost $25 billion in unspent money – $5 billion more than it was designed to hold.
About half of applicants who were deemed to have an outstanding application for the National Health and Medical Research Council’s annual “ideas grants” – scoring six out of seven points – were denied grants. It is a sign that projects of merit in Australia are missing out as a larger number of researchers compete each year for a relatively static amount of money.
More Australian researchers are applying for grants each year, but the amount of money available has stayed relatively static.
The research council gives out about $250 million each year to support innovative and creative health and medical research. Data for 2025 shows that 91.9 per cent of applications for the ideas grants were unsuccessful: there were just 190 funded projects from 2347 applicants.
The 8.1 per cent success rate last year represented a decline from the 10.1 per cent success rate for ideas grants in 2024, and the 11.1 per cent success rate in 2023.
The diminishing success rate is leading crossbenchers, science bodies and medical associations to demand the Albanese government unleash extra money from its Medical Research Future Fund to support more domestic projects, particularly as the Trump administration’s cuts to scientific and medical organisations disrupts research funding around the world.
The original plan was for the Medical Research Future Fund, established by the former Coalition government, to disburse about $1 billion annually once it reached maturity at $20 billion. But that has not happened, and the government is instead releasing $650 million a year.
Loading
Parliamentary Budget Office costings commissioned by independent MP Monique Ryan in September last year show the fund could lift its annual disbursements to Australian researchers to as much as $1.4 billion annually, without making a dent to a base level of $24.5 billion over the next 10 years. It has since grown to $24.8 billion.
“Australia’s leading researchers are missing out on government support for world-class proposals, leaving exceptional talent uncertain about their future. The government cannot claim medical research is a priority while failing to treat it as one,” Ryan said.
“There’s precedent for using the Medical Research Future Fund to supplement [research council] allocations. We have hundreds of millions of unspent dollars in the MRFF, while researchers are unable to secure their careers, cement their futures, and improve Australians’ health.
“Preparing a grant application takes months of work, but I understand that more than half the projects rated ‘outstanding’ in the most recent grant round were unsuccessful – they received no funding.
“What are we telling our researchers when we say their work is outstanding, but we don’t value it enough to support it?”
Professor Steve Wesselingh, the chief executive of the NHMRC, said the drop came from higher demand for grants, combined with applications for larger sums of money.
“That amount that we give out [$250 million per year] has essentially stayed static over time apart from some minor indexation,” he told Senate estimates last month, under questioning from independent senator David Pocock.
“But what we have seen is an increase in numbers of applications, and we have also seen an increase in the size of applications, so the amount of money that people are asking for in the grants has gone up significantly over the last few years, as has the number of applications.”
Wesselingh said the rejection rate for the “outstanding” applications did not necessarily mean the researchers never received funding, because they may have been successful in other processes.
But he acknowledged the sector wanted more money dispersed. “We are in the process right now with the department, chaired by Rosemary Huxtable, of developing a medical health and research strategy,” he said.
“As that strategy is developed... we should be looking at the strategic goals of health and medical research and the resources required to achieve those goals.
“It’s likely that you would see, within that strategy, that more resource given to health and medical research would increase innovation and increase health productivity in the country.”
Loading
Pocock said it was important Australia retained world-class researchers who spent their time doing life-changing study, “rather than filling out endless forms or spending hours on grant applications that are ultimately unsuccessful despite being assessed as meritorious”.
He is pushing for the government to lift its annual disbursements from the medical fund alongside Ryan and independent MPs Helen Haines, Kate Chaney, Sophie Scamps, Allegra Spender and Zali Steggall.
It comes as the Trump administration hollows out US research and medical institutions, including the Centre for Disease Control, the Food and Drug Administration, and the National Institutes of Health, which is the largest public funder of biomedical research in the world.
Most Viewed in Politics
Loading


















































